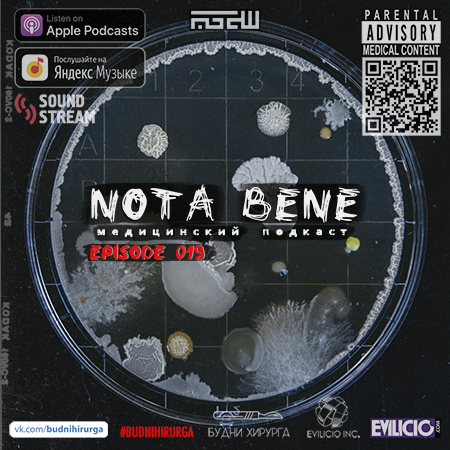
Nota Bene 019 - Бактерия Синтия - Синяя чума

Discover
Nota Bene - Будни Хирурга
Nota Bene - Будни Хирурга
Author: Evilicio inc.
Subscribed: 104Played: 988Subscribe
Share
2026 © Evilicio inc.. Все права защищены.
Description
Дочерний подкаст
NOTA BENE: Будни Хирурга
Подкаст-доза научного адреналина. Забудьте о сухих учебниках — здесь медицина оживает.
Здесь нет скучных лекций — только жёсткие медицинские факты, поданные как крутой сторителлинг.
В данном подкасте буду рассказывать вам про:
шокирующие открытия, исторические методы, от которых волосы встают дыбом, спорные случаи из мировой практики, великие открытия в области медицины, заболевания, вирусы, синдромы и многое другое интересное.
Подписывайтесь, если хотите понимать медицину, а не бояться её.
Полное погружение - рекомендовано слушать в наушниках.
связь(telegram): evilicio
Хирургия - это бездна совершенства.
26 Episodes
Reverse
Здравствуйте, друзья! Вы слушаете подкаст Nota Bene Будни хирурга 26 выпуск.В этом выпуске мы поговорим об одном из самых удивительных и загадочных феноменов медицины — эффекте плацебо. Почему иногда обычная таблетка из сахара может уменьшить боль, улучшить самочувствие и даже ускорить выздоровление?Оказывается, вера пациента в лечение способна запускать реальные биохимические процессы в организме: выработку эндорфинов, снижение уровня стресса и даже изменение восприятия боли.Мы разберёмся, откуда появилось само слово «плацебо», почему «пустышки» до сих пор используются в клинических исследованиях и какие поразительные эксперименты проводили врачи, чтобы понять силу человеческого ожидания.А ещё поговорим о границе между психологией и настоящей медициной. Иногда оказывается, что наш мозг способен помогать телу исцеляться гораздо сильнее, чем мы привыкли думать._____Дочерний подкаст (Будни Хирурга).Короткие новостные выпуски. Регулярно 1 раз в неделю (каждый понедельник) будут выходить выпуски.Связь:Поддержать донатом можно тут: https://www.tbank.ru/cf/7dvFqpAQgY6VK: https://www.vk.com/budnihirurgaтелеграмм: https://t.me/evilicio
Nota Bene 025Революция в травматологии: как Николай Пирогов изобрел гипс и спас миллионы жизнейДо середины XIX века перелом кости часто означал ампутацию или смерть. Деревянные шины, крахмальные бинты и хрупкие гипсовые формы не могли надежно фиксировать кости, приводя к инвалидности и гангрене. Всё изменил гениальный хирург Николай Пирогов. В 1852 году он разработал гипсовую повязку, которая за 5-10 минут создавала легкий и прочный каркас, идеально повторяющий анатомию. Впервые применённая в Крымской войне, она снизила смертность от сложных переломов в 3-4 раза и стала основой современной ортопедии. Узнайте, как Пирогов превратил «упал, перелом, ампутация» в «упал, перелом, гипс» и навсегда изменил хирургию!_____Дочерний подкаст (Будни Хирурга).Короткие новостные выпуски. Регулярно 1 раз в неделю (каждый понедельник) будут выходить выпуски.Связь:Поддержать донатом можно тут: dzen.ru/domvracha?donate=trueVK: https://www.vk.com/budnihirurgaтелеграмм: https://t.me/evilicio
Цинга: как человечество распутало загадку «морской чумы» и открыло витамин С.На протяжении столетий цинга была кошмаром мореплавателей, солдат и исследователей. Целыми экипажами гибли люди от страшных симптомов: зубы выпадали, тело покрывалось кровоподтёками, а смерть приходила медленно и мучительно. Лишь в XX веке тайна болезни была раскрыта — но путь к этому открытию занял века проб, ошибок и гениальных озарений. В этом выпуске подкаста мы проследим, как: 🔹 Цинга влияла на ход истории — от экспедиций Магеллана до полярных исследований 🔹 Джеймс Линд провёл первый в мире клинический эксперимент с цитрусовыми 🔹 Британский флот стал «лайми», а наука — на шаг ближе к разгадке 🔹 Казимир Функ ввёл понятие «витамины», а Сент-Дьёрди получил Нобелевку за витамин С 🔹 Современная медицина использует эти открытия сегодня Это история не только о болезни, но и о том, как упорство учёных и наблюдения простых людей изменили мир. Приготовьтесь к путешествию сквозь века — от парусных судов до лабораторий, где наконец нашли спасительную «аскорбинку»! 🍊⚗️" ___Дочерний подкаст (Будни Хирурга).Короткие новостные выпуски. Регулярно 1 раз в неделю (каждый понедельник) будут выходить выпуски.Связь:VK: https://www.vk.com/budnihirurgaтелеграмм: https://t.me/evilicio
Выпуск 23й - расскажу про первую женщину - врача в России.Рекомендовано слушать в наушниках или на хорошей акустике для полного погружения в атмосферу подкаста.Варвара Кашеварова-Руднева прошла невероятный путь от неграмотной нищенки до первой женщины в России, получившей звание врача и степень доктора медицины.Выражаю огромную благодарность проекту - сайту "Такие дела". Данная история - статья была использована с сайта takiedela.ru( instagram: @takiedela.ru )Оригинал статьи: https://takiedela.ru/2021/01/varvara-pervaya/___Дочерний подкаст (Будни Хирурга).Короткие новостные выпуски. Регулярно 1 раз в неделю (каждый понедельник) будут выходить выпуски.Связь: https://https//wa.me/message/SUTPX27QFSTEN1insta: https://www.instagram.com/budnihirurgaтелеграмм: https://t.me/evilicioПослушать подкаст можно через сервис soundstream.media, скачать одноименное приложение для айфона или андроида. Все это бесплатно! Так же для тех у кого айфон - можно слушать в родном приложении (Podcast - Подкаст), а также во всех подкастах сервисах (Яндекс музыка, Spotify, Google podcast, VK podcast И так далее).В данном подкасте буду рассказывать вам о новостях в области медицины, рассказы, биографии, новых технологиях, о заболеваниях, интересных медицинских фактах, статьи, клинические разборы итд.#хирургия #врачи #врачинеотложки #врачистуденты #surgeon #surgeonlife #students #больница #студенты #студентымедики #СПБГУ #медицинскийфакультет #медфак #budnihirurga #буднихирурга #москва #жизньпрекрасна #здоровье #подежурству #notabene
<table><tr><td><table><tr><td><img /></td></tr></table>Выпуск 22й - расскажу про Дэвида Филлипа Веттера. Мальчик, страдавший от редкого генетического заболевания, ныне определяемого как тяжёлый комбинированный иммунодефицит. С рождения вынужденный жить в абсолютно стерильной среде, приобрёл всемирную известность благодаря постоянному вниманию масс-медиа. Дочерний подкаст (Будни Хирурга). Короткие новостные выпуски. Регулярно 1 раз в неделю (каждый понедельник) будут выходить выпуски. Связь: telegram: evilicio Послушать подкаст можно через сервис soundstream.media, скачать одноименное приложение для айфона или андроида. Все это бесплатно! Так же для тех у кого айфон - можно слушать в родном приложении (Podcast - Подкаст), а также во всех подкастах сервисах (Яндекс музыка, Spotify, Google podcast, VK podcast итд). В данном подкасте буду рассказывать вам о новостях в области медицины, новых технологиях, о заболеваниях, интересных медицинских фактах, статьи, клинические разборы И так далее. #хирургия #врачи #врачинеотложки #врачистуденты #surgeon #surgeonlife #students #больница #студенты #студентымедики #СПБГУ #медицинскийфакультет #медфак #budnihirurga #буднихирурга #москва #жизньпрекрасна #здоровье #подежурству #notabene ссылка ссылка</td></tr></table>
Выпуск 21й - расскажу про историю Ботокс⠀Дочерний подкаст (Будни Хирурга).Короткие новостные выпуски. Регулярно 1 раз в неделю (каждый понедельник) будут выходить выпуски.Связь: vk.com/budnihirurgaTG: t.me/evilicio⠀Послушать подкаст можно через сервис soundstream.media, скачать одноименное приложение для айфона или андроида. Все это бесплатно! Так же для тех у кого айфон - можно слушать в родном приложении (Podcast - Подкаст), а также во всех подкастах сервисах (Яндекс музыка, Spotify, Google podcast, VK podcast итд).⠀В данном подкасте буду рассказывать вам о новостях в области медицины, новых технологиях, о заболеваниях, интересных медицинских фактах, статьи, клинические разборы И так далее.⠀#хирургия #врачи #врачинеотложки #врачистуденты #surgeon #surgeonlife #students #больница #студенты #студентымедики #СПБГУ #медицинскийфакультет #медфак #budnihirurga #буднихирурга #москва #жизньпрекрасна #здоровье #подежурству #notabene
Выпуск 20й - расскажу про историю Виагры, как? что? зачем?⠀Дочерний подкаст (Будни Хирурга).Короткие новостные выпуски. Регулярно 1 раз в неделю (каждый понедельник) будут выходить выпуски.Связь: vk.com/budnihirurgaTG: t.me/evilicio⠀Послушать подкаст можно через сервис soundstream.media, скачать одноименное приложение для айфона или андроида. Все это бесплатно! Так же для тех у кого айфон - можно слушать в родном приложении (Podcast - Подкаст), в сервисе Яндекс музыка, в vk podcast. Так же в во всех популярных подкаст сервисах.⠀В данном подкасте буду рассказывать вам о новостях в области медицины, новых технологиях, о заболеваниях, интересных медицинских фактах, статьи, клинические разборы И так далее.⠀#хирургия #врачи #врачинеотложки #врачистуденты #surgeon #surgeonlife #students #больница #студенты #студентымедики #СПБГУ #медицинскийфакультет #медфак #budnihirurga #буднихирурга #москва #жизньпрекрасна #здоровье #подежурству #notabene
<table><tr><td><table><tr><td><img /></td></tr></table>Выпуск 19й - расскажу об использовании корпорацией ВР синтетических "нефтеядных" бактерий для ликвидации последствий разлива в Заливе. Про техногенную катастрофу которая произошла 20 апреля 2010 года на платформе Deepwater Horizon в Мексиканском заливе. Про British Petroleum - транснациональную нефтегазовую компанию которая стала основным виновником данной катастрофы и благодаря которой была создана Бактерия Синтия и как все вышло из под контроля. Дочерний подкаст (Будни Хирурга). Короткие новостные выпуски. Регулярно 1 раз в неделю (каждый понедельник) будут выходить выпуски. Связь: ссылка (телеграм) @evilicio Послушать подкаст можно через сервис soundstream.media, скачать одноименное приложение для айфона или андроида. Все это бесплатно! Так же для тех у кого айфон - можно слушать в родном приложении (Podcast - Подкаст), в сервисе Яндекс музыка, в vk podcast. Так же в во всех популярных подкаст сервисах. В данном подкасте буду рассказывать вам о новостях в области медицины, новых технологиях, о заболеваниях, интересных медицинских фактах, статьи, клинические разборы И так далее. #хирургия #врачи #врачинеотложки #врачистуденты #surgeon #surgeonlife #students #больница #студенты #студентымедики #СПБГУ #медицинскийфакультет #медфак #budnihirurga #буднихирурга #москва #жизньпрекрасна #здоровье #подежурству #notabene Instagram.com/budnihirurga</td></tr></table>
<table><tr><td><table><tr><td><img /></td></tr></table>Выпуск 18й - расскажу про замечательного хирурга Сергея Сергеевича Юдина, который впервые в истории перелил пациенту кровь, взятую у трупа. Это событие породило современную практику консервирования и длительного хранения донорской крови. Распологайтесь по удобнее, звук по громче... Дочерний подкаст (Будни Хирурга). Короткие новостные выпуски. Регулярно 1 раз в неделю (каждый понедельник) будут выходить выпуски. Связь: ссылка (телеграм) @evilicio Послушать подкаст можно через сервис soundstream.media, скачать одноименное приложение для айфона или андроида. Все это бесплатно! Так же для тех у кого айфон - можно слушать в родном приложении (Podcast - Подкаст), в сервисе Яндекс музыка, в vk podcast. Так же в во всех популярных подкаст сервисах. В данном подкасте буду рассказывать вам о новостях в области медицины, новых технологиях, о заболеваниях, интересных медицинских фактах, статьи, клинические разборы И так далее. #хирургия #врачи #врачинеотложки #врачистуденты #surgeon #surgeonlife #students #больница #студенты #студентымедики #СПБГУ #медицинскийфакультет #медфак #budnihirurga #буднихирурга #москва #жизньпрекрасна #здоровье #подежурству #notabene Instagram.com/budnihirurga Связь: Телеграм: @evilicio</td></tr></table>
<table><tr><td><table><tr><td><img /></td></tr></table>Выпуск 17й - расскажу про возбудитель смертельной болезни, поразившей людоедов форе, усиливается в организме каждого следующего поколения пациентов. Они называли эту болезнь "куру" Распологайтесь по удобнее, звук по громче... Дочерний подкаст (Будни Хирурга). Короткие новостные выпуски. Регулярно 1 раз в неделю (каждый понедельник) будут выходить выпуски. Связь: ссылка (телеграм) @evilicio Послушать подкаст можно через сервис soundstream.media, скачать одноименное приложение для айфона или андроида. Все это бесплатно! Так же для тех у кого айфон - можно слушать в родном приложении (Podcast - Подкаст), в сервисе Яндекс музыка, в vk podcast. Так же в во всех популярных подкаст сервисах. В данном подкасте буду рассказывать вам о новостях в области медицины, новых технологиях, о заболеваниях, интересных медицинских фактах, статьи, клинические разборы И так далее. #хирургия #врачи #врачинеотложки #врачистуденты #surgeon #surgeonlife #students #больница #студенты #студентымедики #СПБГУ #медицинскийфакультет #медфак #budnihirurga #буднихирурга #москва #жизньпрекрасна #здоровье #подежурству #notabene Instagram.com/budnihirurga Связь: ссылка (телеграм) @evilicio</td></tr></table>
<table><tr><td><table><tr><td><img /></td></tr></table>Выпуск 16й - расскажу про катетеризацию сердца. Как обвиненный в шарлатанстве и уволенный врач получил Нобелевскую премию за то, в чем его обвиняли, как он ставил опыты на себе и совершил прорыв в кардиологии. Вернер Форсман - Сельский врач, попавший себе в сердце... Дочерний подкаст (Будни Хирурга). Короткие новостные выпуски. Регулярно 1 раз в неделю (каждый понедельник) будут выходить выпуски. Послушать подкаст можно через сервис soundstream.media, скачать одноименное приложение для айфона или андроида. Все это бесплатно! Так же для тех у кого айфон - можно слушать в родном приложении (Podcast - Подкаст). Так же в во всех популярных подкаст сервисах. В данном подкасте буду рассказывать вам о новостях в области медицины, новых технологиях, о заболеваниях, интересных медицинских фактах, статьи, клинические разборы И так далее. #хирургия #врачи #врачинеотложки #врачистуденты #surgeon #surgeonlife #students #больница #студенты #студентымедики #СПБГУ #медицинскийфакультет #медфак #budnihirurga #буднихирурга #москва #жизньпрекрасна #здоровье #подежурству #notabene Источник: indicator ru Instagram.com/budnihirurga</td></tr></table>
<table><tr><td><table><tr><td><img /></td></tr></table>Выпуск 15й - расскажу про Группы крови. Как? Что? Кем? Карл Ландштейнер. "Кровавая" премия. Дочерний подкаст (Будни Хирурга). Короткие новостные выпуски. Регулярно 1 раз в неделю (каждый понедельник) будут выходить выпуски. Послушать подкаст можно через сервис soundstream.media, скачать одноименное приложение для айфона или андроида. Все это бесплатно! Так же для тех у кого айфон - можно слушать в родном приложении (Podcast - Подкаст). Так же в во всех популярных подкаст сервисах. В данном подкасте буду рассказывать вам о новостях в области медицины, новых технологиях, о заболеваниях, интересных медицинских фактах, статьи, клинические разборы И так далее. #хирургия #врачи #врачинеотложки #врачистуденты #surgeon #surgeonlife #students #больница #студенты #студентымедики #СПБГУ #медицинскийфакультет #медфак #budnihirurga #буднихирурга #москва #жизньпрекрасна #здоровье #подежурству #notabene Источник: ссылка Instagram.com/budnihirurga</td></tr></table>
<table><tr><td><table><tr><td><img /></td></tr></table>Выпуск 14й - расскажу про Врачей - серийных убийц... врачи маньяки, которые оставили свой след в истории... Дочерний подкаст (Будни Хирурга). Короткие новостные выпуски. Регулярно 1 раз в неделю (каждый понедельник) будут выходить выпуски. Послушать подкаст можно через сервис soundstream.media, скачать одноименное приложение для айфона или андроида. Все это бесплатно! Так же для тех у кого айфон - можно слушать в родном приложении (Podcast - Подкаст). Так же в во всех популярных подкаст сервисах. В данном подкасте буду рассказывать вам о новостях в области медицины, новых технологиях, о заболеваниях, интересных медицинских фактах, статьи, клинические разборы И так далее. #хирургия #врачи #врачинеотложки #врачистуденты #surgeon #surgeonlife #students #больница #студенты #студентымедики #СПБГУ #медицинскийфакультет #медфак #budnihirurga #буднихирурга #москва #жизньпрекрасна #здоровье #подежурству #notabene Instagram.com/budnihirurga</td></tr></table>
<table><tr><td><table><tr><td><img /></td></tr></table>Выпуск 13й - расскажу про Конверсию в хирургии... Что это? зачем это? почему это?... Дочерний подкаст (Будни Хирурга). Короткие новостные выпуски. Регулярно 1 раз в неделю (каждый понедельник) будут выходить выпуски. Послушать подкаст можно через сервис soundstream.media, скачать одноименное приложение для айфона или андроида. Все это бесплатно! Так же для тех у кого айфон - можно слушать в родном приложении (Podcast - Подкаст). Так же в во всех популярных подкаст сервисах. В данном подкасте буду рассказывать вам о новостях в области медицины, новых технологиях, о заболеваниях, интересных медицинских фактах, статьи, клинические разборы И так далее. #хирургия #врачи #врачинеотложки #врачистуденты #surgeon #surgeonlife #students #больница #студенты #студентымедики #СПБГУ #медицинскийфакультет #медфак #budnihirurga #буднихирурга #москва #жизньпрекрасна #здоровье #подежурству #notabene Instagram.com/budnihirurga</td></tr></table>
<table><tr><td><table><tr><td><img /></td></tr></table>Выпуск 12й - расскажу про такого выдающегося человека как Рене Лаэннек и истории создания Стетоскопа... Рене Лаэннек - человек который услышал болезнь... Дочерний подкаст (Будни Хирурга). Короткие новостные выпуски. Регулярно 1 раз в неделю (каждый понедельник) будут выходить выпуски. Послушать подкаст можно через сервис soundstream.media, скачать одноименное приложение для айфона или андроида. Все это бесплатно! Так же для тех у кого айфон - можно слушать в родном приложении (Podcast - Подкаст). Так же в во всех популярных подкаст сервисах. В данном подкасте буду рассказывать вам о новостях в области медицины, новых технологиях, о заболеваниях, интересных медицинских фактах, статьи, клинические разборы И так далее. #хирургия #врачи #врачинеотложки #врачистуденты #surgeon #surgeonlife #students #больница #студенты #студентымедики #СПБГУ #медицинскийфакультет #медфак #budnihirurga #буднихирурга #москва #жизньпрекрасна #здоровье #подежурству #notabene Instagram.com/budnihirurga</td></tr></table>
<table><tr><td><table><tr><td><img /></td></tr></table>Выпуск 11й - расскажу про Викторианскую эпоху, а именно про эпоху хирургии в это время... Дочерний подкаст (Будни Хирурга). Короткие новостные выпуски. Регулярно 1 раз в неделю (каждый понедельник) будут выходить выпуски. Послушать подкаст можно через сервис soundstream.media, скачать одноименное приложение для айфона или андроида. Все это бесплатно! Так же для тех у кого айфон - можно слушать в родном приложении (Podcast - Подкаст). В данном подкасте буду рассказывать вам о новостях в области медицины, новых технологиях, о заболеваниях, интересных медицинских фактах, статьи, клинические разборы И так далее. #хирургия #врачи #врачинеотложки #врачистуденты #surgeon #surgeonlife #students #больница #студенты #студентымедики #СПБГУ #медицинскийфакультет #медфак #budnihirurga #буднихирурга #москва #жизньпрекрасна #здоровье #подежурству #notabene Instagram.com/budnihirurga</td></tr></table>
<table><tr><td><table><tr><td><img /></td></tr></table>Выпуск 10й - расскажу про ЭКО (Экстракорпоральное оплодотворение). Дочерний подкаст (Будни Хирурга). Короткие новостные выпуски. Регулярно 1 раз в неделю (каждую пятницу) будут выходить выпуски. Послушать подкаст можно черещ сервис soundstream.media, скачать одноимееное приложение для айфона или андроида. Все это бесплатно! Так же для тех у кого айфон - можно слушать в родном приложении (Podcast - Подкаст). В данном подкасте буду рассказывать вам о новостях в области медицины, новых технологиях, о заболеваниях, интересных медицинских фактах, статьи, клинические разборы И так далее. #хирургия #врачи #врачинеотложки #врачистуденты #surgeon #surgeonlife #students #больница #студенты #студентымедики #СПБГУ #медицинскийфакультет #медфак #budnihirurga #буднихирурга #москва #жизньпрекрасна #здоровье #подежурству #notabene</td></tr></table>
<table><tr><td><table><tr><td><img /></td></tr></table>Выпуск 9й - расскажу про Антибиотики и мифы. Дочерний подкаст (Будни Хирурга). Короткие новостные выпуски. Регулярно 1 раз в неделю (каждую пятницу) будут выходить выпуски. Послушать подкаст можно черещ сервис soundstream.media, скачать одноимееное приложение для айфона или андроида. Все это бесплатно! Так же для тех у кого айфон - можно слушать в родном приложении (Podcast - Подкаст). В данном подкасте буду рассказывать вам о новостях в области медицины, новых технологиях, о заболеваниях, интересных медицинских фактах, статьи, клинические разборы И так далее. #хирургия #врачи #врачинеотложки #врачистуденты #surgeon #surgeonlife #students #больница #студенты #студентымедики #СПБГУ #медицинскийфакультет #медфак #budnihirurga #буднихирурга #москва #жизньпрекрасна #здоровье #подежурству #notabene Instagram.com/budnihirurga</td></tr></table>
<table><tr><td><table><tr><td><img /></td></tr></table>Выпуск 8й - расскажу про Теодора Бильрота. Про первую резекция желудка. Про уникального человека - хирурга. Дочерний подкаст (Будни Хирурга). Короткие новостные выпуски. Регулярно 1 раз в неделю (каждую пятницу) будут выходить выпуски. В данном подкасте буду рассказывать вам о новостях в области медицины, новых технологиях, о заболеваниях, интересных медицинских фактах, статьи, клинические разборы И так далее. #хирургия #врачи #врачинеотложки #врачистуденты #surgeon #surgeonlife #students #больница #студенты #студентымедики #СПБГУ #медицинскийфакультет #медфак #budnihirurga #буднихирурга #москва #жизньпрекрасна #здоровье #подежурству #notabene Instagram.com/budnihirurga</td></tr></table>
<table><tr><td><table><tr><td><img /></td></tr></table>Выпуск 7й - расскажу про Отсроченная "эвтаназию". Мир несправедлив, в нем слишком много смертельно больных детей. Но особенно страшно, когда страдают и гибнут дети, которым можно было помочь. Современная медицина ушла далеко вперед, но в России ее достижения доходят далеко не до каждого. И нередко виной этому даже не прижимистость или неповоротливость государства, а человеческий фактор Дочерний подкаст (Будни Хирурга). Короткие новостные выпуски. Регулярно 1 раз в неделю (каждую пятницу) будут выходить выпуски. В данном подкасте буду рассказывать вам о новостях в области медицины, новых технологиях, о заболеваниях, интересных медицинских фактах, статьи, клинические разборы И так далее. #хирургия #врачи #врачинеотложки #врачистуденты #surgeon #surgeonlife #students #больница #студенты #студентымедики #СПБГУ #медицинскийфакультет #медфак #budnihirurga #буднихирурга #москва #жизньпрекрасна #здоровье #подежурству #notabene Instagram.com/budnihirurga</td></tr></table>